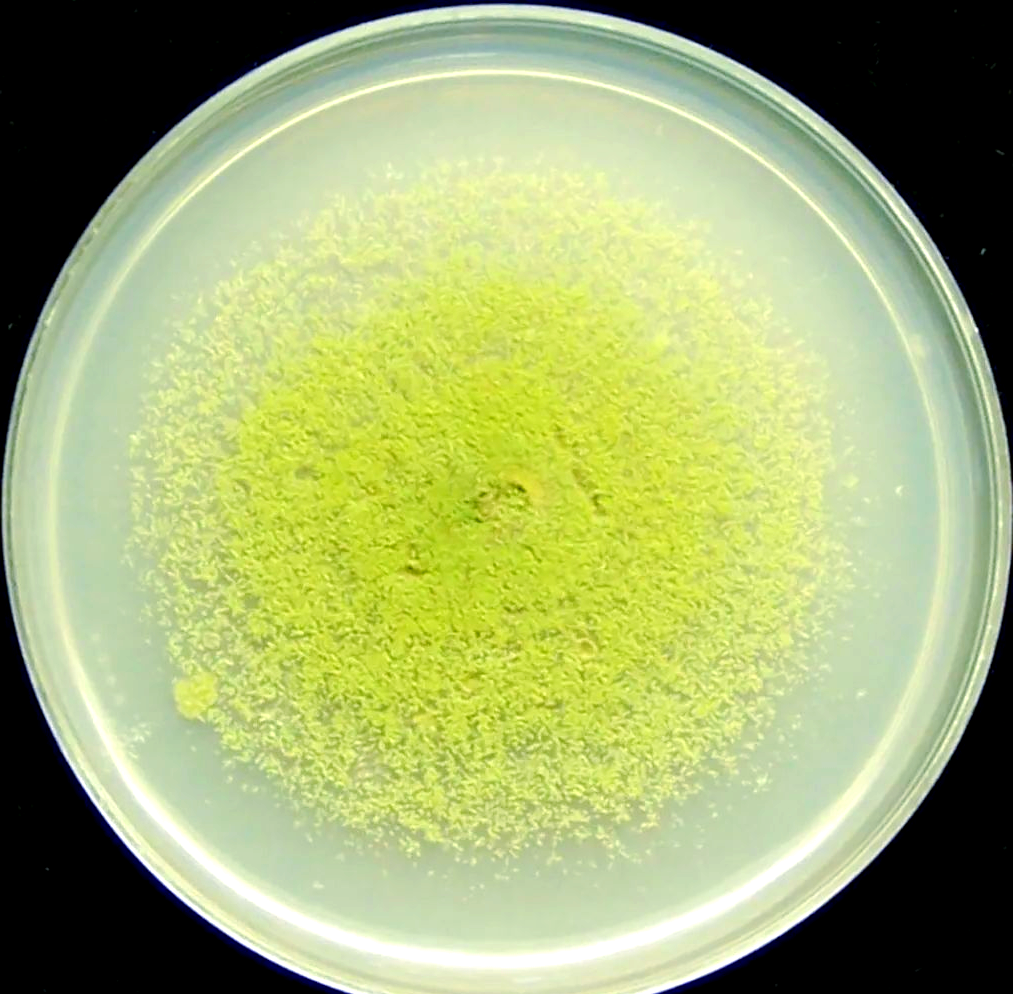
当心!散装油中的黄曲霉毒素从哪里来?...

黄曲霉素从哪里长出来 如何去除黄曲霉素
黄曲霉素是从哪里长出来的
黄曲霉素是黄曲霉、寄生曲霉等霉菌产生的代谢产物,这可真是无处不在的坏东西啊!当粮食没能及时晒干或者储存不当的时候,就特别容易被这些霉菌污染。它们不仅藏在土壤里,还特别喜欢在各种坚果里安家,特别是花生和核桃,简直防不胜防。大豆、稻谷、玉米、通心粉、调味品、牛奶、奶制品、食用油等制品中也经常能发现它们的踪迹。一般来说,热带和亚热带地区因为气候潮湿,黄曲霉素的检出率更高。在中国,华中、华南、华北地区的产毒株多,产毒量也大,这些地方的食品风险相对较高。

黄曲霉素的危害和预防方法
-
黄曲霉素对人体危害超大:这玩意儿毒性极强,是砒霜的68倍!主要损害人体的肝脏,长期摄入可能导致肝癌、胃癌等严重疾病。还可能对神经系统、免疫系统造成损害,真是可怕极了。
-
食用油安全问题要特别注意:品牌花生油虽然含有少量黄曲霉素,但对人体的危害相对可控。而土榨花生油很可能含有大量黄曲霉素,因为作坊可能会使用变质的花生原料。自制的所谓"天然无添加"食用油,如果原料被污染,也可能导致黄曲霉素含量超标。
-
去除黄曲霉素有妙招:家庭中最简单快捷的方法是在煮花生时加点食用碱,用高压电饭煲可彻底破坏黄曲霉毒素。熬八宝粥时加点食用碱,不仅能破坏各种豆类和花生中的黄曲霉毒素,还能保护杂粮中的维生素,一举两得!
-
选购和储存要点:建议购买正规超市销售的植物油,这些都是按照国家标准生产的,黄曲霉毒素含量较低。家里的花生、核桃、玉米、奶制品、调味料、食用油等物品一旦过期,要立即丢弃,千万别舍不得!
-
喜欢土榨油怎么办:如果确实喜欢吃土榨花生油,可以自己挑选品质好的花生原料,选择卫生条件好的作坊,也可以买家庭用的榨油机,这样能最大程度减少黄曲霉素的产生。
相关问题解答
- 黄曲霉素主要藏在哪些食物里?
哎呀,这个问题可重要了!黄曲霉素最喜欢藏在发霉的粮食和坚果里,特别是花生和核桃这些油性大的食物。玉米、大米、小麦这些谷物也是它的"大本营",还有啊,通心粉、调味品这些加工食品如果储存不当也会中招。最要命的是奶制品和食用油,如果原料被污染了,那成品里肯定少不了这坏东西。所以大家一定要检查食品的新鲜度,发霉的东西千万不能吃哦!
- 怎么判断食用油是否含有黄曲霉素?
说实话,普通人在家很难直接判断,因为黄曲霉素无色无味,肉眼根本看不出来。但是有个小窍门:如果你买的是土榨油或者自制油,一定要闻一闻有没有霉味或者哈喇味。最好的办法还是买正规品牌的食用油,这些都有严格的质量检测。要是发现油的颜色特别深或者有沉淀物,那就要小心了,赶紧换掉别用了!
- 吃到了含黄曲霉素的食物怎么办?
天呐,如果只是不小心吃了一点点,不用太慌张,人体有一定的解毒能力。但要是吃多了或者经常吃,那可就麻烦大了!建议多喝水帮助排毒,可以吃一些富含膳食纤维的食物。如果出现恶心、呕吐等症状,一定要及时就医。最重要的是以后要更加注意食品卫生,发霉变质的食物直接扔掉,别心疼那点钱!
- 如何预防黄曲霉素中毒?
预防最重要啦!首先要保持食物干燥,粮食要晒干后再储存。买坚果时要选新鲜的,闻起来没有霉味的。食用油一定要买正规厂家生产的,别贪便宜买来路不明的土榨油。家里的食物要定期检查,过期的赶紧处理掉。还有啊,厨房要保持干燥通风,这样霉菌就不容易生长了。记住这些,就能大大降低中毒风险啦!
添加评论